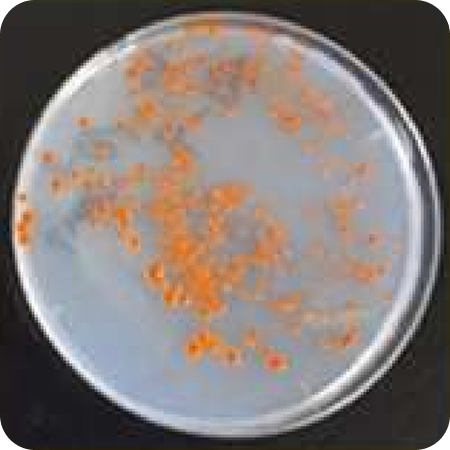

R&DSUPPORT助成金制度
MaOI機構が提供する助成金制度を、
ステージ別にご紹介します。
・Feasibility Study
・Promotion of Marine Technology Development
・Promotion of Marine-Related Business Development
・Research for Seed Creation
Grant applications are accepted only in Japanese,
and instructions for applying to each grant are provided solely in Japanese.
試作・検証したい
フィージビリティ・
スタディ(MaOI-FS)
- 限度額:150万円
- 補助率:2/3以内
- 対象期間:1年以内
事業アイデアの検証、試作、データ取得など“初期の実証”に活用できる支援制度です。
概要
-
補助対象者
中小企業者及び農林漁業者(静岡県内)
-
補助対象事業
アイデア等を具体化する部品・製品・ソフトウェアの開発や試作品の開発、データ等の取得など。
-
補助対象経費
事業化のための取組に要する経費(原材料費、機械装置購入費、外注費等)※人件費は対象外
-
特徴
小額から活用しやすい、初期支援制度です。幅広い事業経費を対象としているので、次のステップにつなげるための検討段階に活用できます。
支援事例
フィージビリティ・スタディ について相談できます
研究・探索したい シーズ創出研究後業務委託
- 限度額:500万円/年※条件を満たす場合1,000万円/年
- 補助率:ー
- 対象期間:3年以内
海洋分野の新たな研究シーズ創出に向けた委託研究制度です。
概要
-
補助対象者
法人格を有する大学等研究機関、又は企業や静岡県試験研究機関等とのコンソーシアム
-
補助対象事業
マーケットインの視点に立った静岡県の産業の成長発展につながる研究、海洋分野における国際的な課題解決に資する研究など
-
補助対象経費
研究活動に要する経費(原材料費、機械装置購入費、外注費、人件費等の直接経費及び間接経費)
-
特徴
研究業務の委託を行います。研究に係る費用のすべてを限度額の範囲内で提供します。
支援事例

内浦湾の環境モニタリングによるマアジのへい死メカニズムの解明
慶應義塾大学理工学部
低酸素応答制御機能を持つ静岡県産魚類由来成分の探索と疾患制御に関する研究
慶應義塾大学医学部眼科学教室
海洋環境ワイヤレスモニタリングのための微生物燃料電池の開発
東京科学大学生命理工学院
動画撮影とAI認識による駿河湾サクラエビ漁業支援システムの開発
東海大学海洋学部
海洋細菌のもつ生理活性を利活用する研究
高知大学農林海洋科学部
深海環境において生分解性を示すバイオプラスチックの構造探索
東京工業大学 / 静岡県水産・海洋技術研究所
分子情報に基づくキンメダイ飼育技術の構築
東京海洋大学 / 静岡県水産・海洋技術研究所
駿河湾由来カロテノイド生産微生物の探索とサプリメント開発への応用
静岡県立大学 / はごろもフーズ株式会社 / 静岡県工業技術研究所
静岡県産魚類由来成分の探索と失明疾患制御に関する研究
慶應義塾大学 / 静岡県水産・海洋技術研究所 / 静岡大学グリーン科学技術研究所シーズ創出研究後業務委託 について相談できます
技術を開発したい 海洋技術開発促進事業費補助金
- 限度額:1,000万円/年
- 補助率:2/3以内
- 対象期間:2年以内
海洋分野の工学・情報系技術開発を支援する補助制度です。
概要
-
補助対象者
大学等と連携して技術開発を実施する静岡県内の企業
-
補助対象事業
マリンバイオテクノロジーを活用した「食品」「水産」「創薬」及び「環境・エネルギー」等の分野の産業振興の基盤となる工学系・情報系の技術開発
-
補助対象経費
事業化のための取組に要する経費(原材料費、機械装置購入等経費、外注加工費、技術コンサルタント料等)※人件費は対象外
-
特徴
企業と大学の連携による技術開発の基礎研究活動を支援します
支援事例
海洋技術開発促進事業費補助金 について相談できます
事業化したい
マリンオープンイノベーション
事業化促進事業費補助金
- 限度額:500万円/年
- 補助率:1/2以内
-
対象期間:
3年以内(DX推進枠)
2年以内(海プラ6R枠)
海洋資源を活用した製品・サービスの事業化を支援する補助制度です。
概要
-
補助対象者
民間事業者二者以上で構成された「コンソーシアム」
(半数以上は静岡県内の民間事業) -
補助対象事業
「水産」「食品」「創薬」及び「環境・エネルギー」等の分野におけるマリンバイオテクノロジーを活用した事業化の取組
-
補助対象経費
事業化のために要する経費(原材料費、機械装置購入費、外注費等)※人件費は対象外
-
特徴
社会実装に向けた企業の事業化の取り組みを支援します。「DX推進枠」と「海洋プラ6R推進枠」の2種類があります。
支援事例

熱海沖で採取された海洋酵母が産生する新規カロテノイドの化粧品原料としての事業化
ケイ・アイ化成株式会社
海洋性「アンセリン」による血圧と尿酸値を同時に改善する“日本初”の機能性表示食品の開発
焼津水産化学工業株式会社
マグロ頭未利用部位からのペプチドグリカン抽出技術の確立とその用途開発
株式会社Dr.シーバ(焼津市) / 株式会社女性イキイキカンパニー / 静岡県立大学 静岡県工業技術研究所
超高齢化社会の課題である認知機能維持に寄与する機能性表示食品の開発事業
三生医薬株式会社 / はごろもフーズ株式会社
鯖発酵調味料の製品化による特徴ある地域ブランド新製品開発
株式会社岩清 / 焼津水産加工協同組合
浸透圧調節等を利用した安全で美味しいニジマス養殖技術「味上げ」の開発とブランド化
柿島養鱒株式会社 / 株式会社テクノスルガ・ラボ / 株式会社ニチモウマリカルチャー / 東京大学 理化学研究所 アグリオープンイノベーション機構
電気分解を応用した魚介類の陸上養殖(閉鎖循環式)の高生産化に寄与する技術開発
株式会社イノベーティブデザイン&テクノロジー 澤の金魚屋 東海大学海洋学部
駿河湾から生まれた高保湿化粧水の開発
株式会社GOLDBLUE 株式会社Dr.シーバ
マリンオープンイノベーション
事業化促進事業費補助金
について相談できます
FAQ
よくある質問
-
QMaOI(マリンオープンイノベーション機構)とは何ですか?
AMaOI(マリンオープンイノベーション)機構とは、静岡県の進めるオープンイノベーションプロジェクトの一環として、海洋産業の振興と海洋環境の保全を両立するBlue Economyの世界的な拠点を目指すために、静岡県の100%出資によって設立された一般財団法人です。
-
Qどのような支援制度がありますか?
A助成金制度による支援のほか、企業の様々な課題解決のためのネットワーキングの支援、さらには実海域を使用した実証実験のための支援も行っています。
-
Q企業と研究機関、どちらでも利用できますか?
Aはい、どちらでもご利用いただけます。企業・研究機関向けに様々な支援制度を用意しております。MaOI機構ではMaOI機構研究所において海洋生物のゲノム関連研究をはじめとした独自研究も行っていますので、共同研究のご相談も受け付けています。
-
Q支援を受けるための応募条件を教えてください
A助成金制度を利用する場合は、MaOIフォーラムの会員であることなどが条件となっています。それ以外の支援については特に条件はありません。まずはお気軽にご相談ください。
-
Q申請の際に必要な書類や手続きの流れはありますか?
A助成金制度や実証実験については申請書類が必要となります。利用を検討されている場合は、まずは御相談ください。
まずはお気軽にご相談ください














